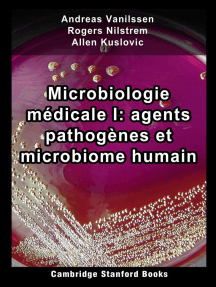

Microbiologie médicale I: agents pathogènes et microbiome humain
5/5
()
À propos de ce livre électronique
Il existe plusieurs voies par lesquelles les agents pathogènes peuvent envahir un hôte. Les voies principales ont des périodes épisodiques différentes, mais le sol a le potentiel le plus long ou le plus persistant d'abriter un agent pathogène. Les maladies humaines causées par des agents infectieux sont appelées maladies pathogènes. Le microbiome humain est l’agrégat de tous les microbiota qui résident sur ou dans les tissus humains et les biofluides ainsi que les sites anatomiques correspondants dans lesquels ils résident, y compris la peau, les glandes mammaires, le placenta, le liquide séminal, l'utérus, les follicules ovariens, les poumons, la salive, la muqueuse buccale, la conjonctive, les voies biliaires et tube digestif. Contenu de ce livre: Pathogène, Prion, Virus, Bactéries pathogènes, Champignon, Champignon pathogène, Parasite humain, Protozoaires, Ver parasite, Liste des parasites humains, microbiologie clinique, Interaction hôte-pathogène, Maladie infectieuse, Liste des maladies infectieuses, Infections associé à des maladies, microbiome humain, projet sur le microbiome humain, hypothèse de la santé de la biodiversité, acquisition initiale de microbiota, virome humain, gastro-intestinal humain microbiota, Axe intestin-cerveau, Psychobiotique, Résistance à la colonisation, Flore cutanée, Flore vaginale, Flore vaginale pendant la grossesse, Liste des vaginoses bactériennes microbiota, Microbiome placentaire, Microbiome du lait humain, Écologie orale, Microbiome salivaire, Poumon microbiota, Liste des humain microbiota, Probiotique, Probiotiques chez l'enfant, Psychobiotique, Bacillus clausii, Postbiotique, Protéobiotiques, Synbiotiques, Bacillus coagulans, Vaginose bactérienne, Bifidobacterium animalis, Bifidobactérie bifidum, Bifidobacterium breve, Bifidobacterium longum bifidum, Bifidobacterium breve, Bifidobacterium longum, Botryosphaeran, Clostridium butyricum, Escherichia coli Nissle 1917, facteur de transcription Gal4, Ganeden, Lactinex, Lactobacillus acidophilus, Lactobacillus casei, Lactobacillus crispatus .
Authors: Andreas Vanilssen, Rogers Nilstrem, Allen Kuslovic
Lié à Microbiologie médicale I
Livres électroniques liés
266 Pilules De Pharmacologie Évaluation : 0 sur 5 étoiles0 évaluationApprendre La Pharmacologie En Une Semaine Évaluation : 0 sur 5 étoiles0 évaluationLa Fièvre Typhoïde: Histoire de la médecine Évaluation : 0 sur 5 étoiles0 évaluationSystème Cardiovasculaire I Évaluation : 0 sur 5 étoiles0 évaluationMicrobiologie médicale II: stérilisation, diagnostic de laboratoire et réponse immunitaire Évaluation : 0 sur 5 étoiles0 évaluation1200 Tests De Pharmacologie Évaluation : 0 sur 5 étoiles0 évaluationPrise en soins de patients: L'inévitable contre-transfert Évaluation : 5 sur 5 étoiles5/5Cathéter(s) Évaluation : 0 sur 5 étoiles0 évaluationVotre programme pour la prévention et le traitement naturel de la scoliose: Prenez votre sante en main Évaluation : 0 sur 5 étoiles0 évaluationLes cancers de l'utérus: Une brochure de la Fondation contre le Cancer Évaluation : 0 sur 5 étoiles0 évaluationCe qu'il faut savoir sur l'hypertension artérielle: expliqué simplement Évaluation : 5 sur 5 étoiles5/5Appareil génital: Les Grands Articles d'Universalis Évaluation : 0 sur 5 étoiles0 évaluationAnatomie Humaine: Un Manuel Pratique et Intuitif pour Découvrir le Corps Humain et Toutes ses Composantes Évaluation : 0 sur 5 étoiles0 évaluationMembranes cellulaires: Les Grands Articles d'Universalis Évaluation : 0 sur 5 étoiles0 évaluationPharmacologie: Les Grands Articles d'Universalis Évaluation : 0 sur 5 étoiles0 évaluationInterprétation d'un ECG: Un Guide Pratique et Intuitif pour Apprendre à Lire un ECG et pour Diagnostiquer et Traiter les Arythmies Évaluation : 0 sur 5 étoiles0 évaluationFoie: Les Grands Articles d'Universalis Évaluation : 0 sur 5 étoiles0 évaluationLes fondateurs de la Médecine Évaluation : 0 sur 5 étoiles0 évaluationLa désintoxication douce: Programme de détoxification naturelle Évaluation : 5 sur 5 étoiles5/5Les secrets de santé d’une sorcière 2.0 Évaluation : 4 sur 5 étoiles4/5Une introduction à la biostatistique, 2e édition Évaluation : 0 sur 5 étoiles0 évaluationBiologie des Croyances: Comment affranchir la puissance de la conscience, de la matière et des miracles Évaluation : 0 sur 5 étoiles0 évaluationSibo, mes intestins !: Petit guide de méthodes naturelles pour en finir avec les troubles digestifs Évaluation : 0 sur 5 étoiles0 évaluationNeurobiologie: Les Grands Articles d'Universalis Évaluation : 0 sur 5 étoiles0 évaluationLes fondateurs de la Chimie - Jabir Ibn-Hayyan (Geber) - M.I.Z. Ar-Razi (Rhazès) Évaluation : 5 sur 5 étoiles5/5Pasteur, Microbes, Vaccins, la Vérité Évaluation : 1 sur 5 étoiles1/5Le petit docteur: Conseils de santé utiltes Évaluation : 0 sur 5 étoiles0 évaluationSysteme immunitaire En français/ Immune system In French Évaluation : 0 sur 5 étoiles0 évaluation
Médical pour vous
Ma vie et la psychanalyse Évaluation : 4 sur 5 étoiles4/5Essais Évaluation : 0 sur 5 étoiles0 évaluationComprendre la procrastination: Pour obtenir vos objectifs Évaluation : 4 sur 5 étoiles4/5Secrets ancestraux d'un maître guérisseur: Un sceptique occidental, un maître oriental et les plus grands secrets de la vie Évaluation : 5 sur 5 étoiles5/5Interprétation d'un ECG: Un Guide Pratique et Intuitif pour Apprendre à Lire un ECG et pour Diagnostiquer et Traiter les Arythmies Évaluation : 0 sur 5 étoiles0 évaluationL'art d'aimer Évaluation : 0 sur 5 étoiles0 évaluationL'étrange Défaite Évaluation : 0 sur 5 étoiles0 évaluationMagellan Évaluation : 5 sur 5 étoiles5/5Géobiologie de l'habitat et Géobiologie sacrée: Pour un lieu sain Évaluation : 5 sur 5 étoiles5/5Maximiser ses capacités intellectuelles: Techniques et astuces pour exploiter au mieux son mental Évaluation : 4 sur 5 étoiles4/5Anatomie Humaine: Un Manuel Pratique et Intuitif pour Découvrir le Corps Humain et Toutes ses Composantes Évaluation : 0 sur 5 étoiles0 évaluationPetit lexique futile mais nécessaire à l'intention des philosophes et des demeurés Évaluation : 0 sur 5 étoiles0 évaluationMalaise dans la civilisation Évaluation : 0 sur 5 étoiles0 évaluationCerveau et éthique: Au-delà du bien et du mal Évaluation : 0 sur 5 étoiles0 évaluationTraité théologico-politique: Une exploration révolutionnaire de la liberté de penser, de la critique biblique et de la séparation Église-État Évaluation : 0 sur 5 étoiles0 évaluationL'Argent Colloïdal - L'Antibiotique Naturel: L'Alternative Holistique Aux Antibiotiques Nouveau Découvert Évaluation : 0 sur 5 étoiles0 évaluationLes secrets de santé d’une sorcière 2.0 Évaluation : 4 sur 5 étoiles4/5Découvrir les Démons de Votre Esprit Évaluation : 0 sur 5 étoiles0 évaluationLa Respiration Yogique Scientifique: Une approche scientifique pour utiliser les pranayamas et aider vos élèves à régler efficacement leurs plus gros problèmes Évaluation : 0 sur 5 étoiles0 évaluationL'alcoolisme est-il une fatalité ?: Comprendre et inverser une spirale infernale Évaluation : 0 sur 5 étoiles0 évaluationPaléo : ce n'est pas un régime, c'est un mode de vie Évaluation : 0 sur 5 étoiles0 évaluationL' ESPRIT EST SON PROPRE MÉDECIN: Le pouvoir de guérison de la méditation Évaluation : 0 sur 5 étoiles0 évaluationLe mot d'esprit et ses rapports avec l'inconscient Évaluation : 0 sur 5 étoiles0 évaluationPremiers Secours: un manuel pratique pour faire face aux urgences Évaluation : 0 sur 5 étoiles0 évaluation
Avis sur Microbiologie médicale I
1 notation0 avis
Aperçu du livre
Microbiologie médicale I - Andreas Vanilssen
Microbiologie médicale
La microbiologie médicale, le vaste sous-ensemble de la microbiologie appliquée à la médecine, est une branche de la science médicale qui s'intéresse à la prévention, au diagnostic et au traitement des maladies infectieuses. De plus, ce domaine scientifique étudie diverses applications cliniques des microbes pour l'amélioration de la santé. Il existe quatre types de micro-organismes qui causent des maladies infectieuses: les bactéries, les champignons, les parasites et les virus, et un type de protéine infectieuse appelée prion.
Un microbiologiste médical étudie les caractéristiques des agents pathogènes, leurs modes de transmission, les mécanismes d'infection et de croissance. En utilisant ces informations, un traitement peut être conçu. Les microbiologistes médicaux servent souvent de consultants pour les médecins, fournissant l'identification des agents pathogènes et suggérant des options de traitement.Les autres tâches peuvent inclure l'identification des risques potentiels pour la santé de la communauté ou le suivi de l'évolution de souches de microbes potentiellement virulentes ou résistantes, l'éducation de la communauté et l'aide à la conception des pratiques de santé. Ils peuvent également aider à prévenir ou à contrôler les épidémies et les flambées de maladie. Tous les microbiologistes médicaux n'étudient pas la pathologie microbienne; certains étudient des espèces communes non pathogènes pour déterminer si leurs propriétés peuvent être utilisées pour développer des antibiotiques ou d'autres méthodes de traitement.
L'épidémiologie, l'étude des modèles, des causes et des effets de la santé et de toutes les conditions dans les populations, est une partie importante de la microbiologie médicale, malgré la caractéristique clinique du domaine se concentre fondamentalement sur la présence et la croissance des infections microbiennes chez les individus, leurs effets sur le corps humain et les méthodes de traitement de ces infections. Dans ce contexte, l'ensemble du domaine, en tant que science appliquée, peut être subdivisé conceptuellement en sous-spécialités académiques et cliniques, même s'il existe en réalité un continuum fluide entre la microbiologie de la santé publique et la microbiologie médicale diagnostique, tout comme l'état de l'art. dans les laboratoires cliniques dépend de l'amélioration continue de la médecine universitaire et des laboratoires de recherche.
Maladies infectieuses couramment traitées
Bactérien
Pharyngite streptococcique
Chlamydia
La fièvre typhoïde
Tuberculose
Viral
Rotavirus
Hépatite C
Humain papillomavirus ( HPV)
Parasite
Paludisme
Giardia lamblia
Toxoplasma gondii
Fongique
Candidose
Histoplasmose
Causes et transmission des maladies infectieuses
Les infections peuvent être causées par des bactéries, des es, des champignons et des parasites. L'agent pathogène qui cause la maladie peut être exogène (acquis d'une source externe; environnemental, animal ou autre, par exemple grippe) ou endogène (de la flore normale, par exemple candidose).
Le site par lequel un microbe pénètre dans le corps est appelé la porte d'entrée. Ceux-ci comprennent les voies respiratoires, le tractus gastro-intestinal, le tractus génito-urinaire, la peau et les muqueuses. Le portail d'entrée d'un microbe spécifique dépend principalement de la façon dont il se déplace de son habitat naturel à l'hôte.
Il existe différentes manières de transmettre la maladie entre les individus. Ceux-ci inclus:
Contact direct - Toucher un hôte infecté, y compris un contact sexuel
Contact indirect - Toucher une surface contaminée
Contact de gouttelettes - toux ou éternuements
Voie fécale-orale - Ingestion d'aliments ou de sources d'eau contaminés
Transmission aérienne - Spores porteurs d'agents pathogènes
Transmission vectorielle - Un organisme qui ne cause pas la maladie mais transmet l'infection en transportant des agents pathogènes d'un hôte à un autre
Transmission fomite - Un objet ou une substance inanimée capable de transporter des germes infectieux ou des parasites
Environnemental - Infection nosocomiale (infections nosocomiales)
Comme d'autres agents pathogènes, ils utilisent ces méthodes de transmission pour pénétrer dans le corps, mais ils diffèrent en ce qu'ils doivent également entrer dans les cellules réelles de l'hôte. Une fois qu'il a eu accès aux cellules de l'hôte, le matériel génétique (ARN ou ADN) doit être introduit dans la cellule. La réplication entre les gènes est très variée et dépend du type de gènes impliqués. La plupart des ADN s'assemblent dans le noyau, tandis que la plupart des ARN se développent uniquement dans le cytoplasme.
Les mécanismes d'infection, de prolifération et de persistance d'un dans les cellules de l'hôte sont cruciaux pour sa survie. Par exemple, certaines maladies, comme la rougeole, emploient une stratégie selon laquelle elle doit se propager à une série d'hôtes. Dans ces formes d'infection virale, la maladie est souvent traitée par la propre réponse immunitaire de l'organisme et, par conséquent, doit se disperser vers de nouveaux hôtes avant d'être détruite par une résistance immunologique ou par l'hôte death. Alors que certains agents infectieux, par exemple le félin leukemia, sont capables de résister à des réponses immunitaires et sont capables de parvenir à une résidence à long terme dans un hôte individuel, tout en conservant également la capacité de se propager dans des hôtes successifs.
Tests diagnostiques
L'identification d'un agent infectieux pour une maladie mineure peut être aussi simple que la présentation clinique; par exemple les maladies gastro-intestinales et les infections cutanées. Afin de faire une estimation éclairée du microbe qui pourrait causer la maladie, des facteurs épidémiologiques doivent être pris en considération; par exemple, la probabilité d'exposition du patient à l'organisme suspecté et la présence et la prévalence d'une souche microbienne dans une communauté.
Le diagnostic de maladie infectieuse est presque toujours initié en consultant les antécédents médicaux du patient et en effectuant un examen physique. Des techniques d'identification plus détaillées impliquent la culture microbienne, la microscopie, les tests biochimiques et le génotypage. D'autres techniques moins courantes (comme les rayons X, les scans CAT, les scans PET ou RMN) sont utilisées pour produire des images d'anomalies internes résultant de la croissance d'un agent infectieux.
Culture microbienne
La culture microbiologique est la principale opération utilisée pour isoler les animaux infectieux à étudier en laboratoire. Des échantillons de tissu ou de fluide sont testés pour la présence d'un agent pathogène spécifique, qui est déterminé par croissance dans un milieu sélectif ou différentiel.
Les 3 principaux types de supports utilisés pour les tests sont:
Culture solide: Une surface solide est créée à l'aide d'un mélange de nutriments, de sels et d'agar. Un seul microbe sur une plaque d'agar peut alors se développer en colonies (clones où les cellules sont identiques les unes aux autres) contenant des milliers de cellules. Ceux-ci sont principalement utilisés pour cultiver des bactéries et des champignons.
Culture liquide: Les cellules sont cultivées dans un milieu liquide. La croissance microbienne est déterminée par le temps nécessaire au liquide pour former une suspension colloïdale. Cette technique est utilisée pour diagnostiquer les parasites et détecter mycobacteria .
Culture cellulaire: Les cultures cellulaires humaines ou animales sont infectées par le microbe d'intérêt. Ces cultures sont ensuite observées pour déterminer l'effet du microbe sur les cellules. Cette technique est utilisée pour identifier.
Microscopie
Les techniques de culture utilisent souvent un examen microscopique pour aider à l'identification du microbe. Des instruments, par exemple des microscopes optiques composés, peuvent être utilisés pour évaluer des aspects critiques de l'organisme. Cela peut être effectué immédiatement après le prélèvement de l'échantillon sur le patient et est utilisé en conjonction avec des techniques de coloration biochimique, permettant la résolution des caractéristiques cellulaires. Les microscopes électroniques et les microscopes à fluorescence sont également utilisés pour observer les microbes plus en détail à des fins de recherche.
Tests biochimiques
Des tests biochimiques rapides et relativement simples peuvent être utilisés pour trouver des agents infectieux. Pour l'identification bactérienne, l'utilisation de caractéristiques métaboliques ou enzymatiques est courante parce que leur capacité à fermenter les glucides selon des schémas caractéristiques de leur genre et de leur espèce. Les acides, alcools et gaz sont couramment détectés dans ces tests lorsque les bactéries sont cultivées dans des milieux liquides ou solides sélectifs, comme mentionné ci-dessus. Afin de réaliser ces tests en masse, des machines automatisées sont utilisées. Ces machines effectuent plusieurs tests biochimiques simultanément, en utilisant des cartes avec plusieurs puits contenant des produits chimiques déshydratés disparates. Le microbe d'intérêt réagira avec chaque produit chimique dans un processus spécifique, aidant à son identification.
Les méthodes sérologiques sont des tests de laboratoire très sensibles, spécifiques et souvent extrêmement rapides utilisés pour trouver des types disparates de micro-organismes. Les tests sont basés sur la capacité d'un anticorps à se lier notamment à un antigène. L'antigène (généralement une protéine ou un hydrate de carbone fabriqué par un agent infectieux) est lié par l'anticorps, ce qui permet d'utiliser ce type de test pour des organismes autres que les bactéries. Cette liaison déclenche alors une chaîne d'événements qui peuvent être facilement et définitivement observées, en fonction du test. D'autres techniques sérologiques complex sont connues sous le nom de dosages immunologiques. En utilisant une base similaire à celle décrite ci-dessus, les dosages immunologiques peuvent révéler ou mesurer des antigènes provenant soit d'agents infectieux, soit des protéines générées par un hôte infecté en réponse à l'infection.
Réaction en chaîne par polymérase
Les tests de réaction en chaîne par polymérase( PCR) sont la technique moléculaire la plus couramment utilisée pour révéler et étudier les microbes. Par rapport à d'autres méthodes, le séquençage et l'examen minutieux sont définitifs, fiables, précis et rapides. Aujourd'hui, la technique PCR quantitative est la principale technique utilisée, car cette opération fournit des données plus rapides par rapport à un test standard PCR. Telles que, les techniques PCR traditionnelles nécessitent l'utilisation de gel electrophoresis pour visualiser les molécules DNA amplifiées une fois la réaction terminée. Quantitative PCR ne l'exige pas, car l'ordre établi de détection utilise la fluorescence et des sondes pour révéler le DNA molécules au fur et à mesure de leur amplification. De plus, le PCR quantitatif élimine également le risque de contamination qui peut survenir pendant les procédures standard PCR (report du produit PCR dans les PCR ultérieures). Un autre avantage de l'utilisation de PCR pour révéler et étudier les microbes est que les séquences DNA de microbes ou de souches infectieuses nouvellement découvertes peuvent être comparées à celles déjà répertoriées dans les bases de données, ce qui aide à mieux comprendre quel organisme est à l'origine de l'infection. et par conséquent quelles méthodes de traitement pourraient être utilisées. Cette technique est la norme actuelle pour détecter les infections virales par exemple AIDS et l'hépatite.
Traitements
Une fois qu'une infection a été diagnostiquée et identifiée, les options de traitement appropriées doivent être évaluées par le médecin et les microbiologistes médicaux consultatifs. Certaines infections peuvent être traitées par le propre ordre immunitaire établi du corps, mais les infections plus graves sont traitées avec des médicaments antimicrobiens. Les infections bactériennes sont traitées avec des antibactériens (souvent appelés antibiotiques), tandis que les infections fongiques et virales sont traitées avec des antifongiques et des antiviraux respectivement. Une large classe de médicaments appelés antiparasitaires est utilisée pour traiter les maladies parasitaires.
Les microbiologistes médicaux font souvent des recommandations de traitement au médecin du patient en fonction de la souche du microbe et de ses résistances aux antibiotiques, du site d'infection, de la toxicité potentielle des médicaments antimicrobiens et des allergies médicamenteuses du patient.
En plus des médicaments spécifiques à un certain type d'organisme (bactéries, champignons, etc.), certains médicaments sont spécifiques à un certain genre ou espèce d'organisme et ne fonctionneront pas sur un autre organisme. En raison de cette spécificité, les microbiologistes médicaux doivent tenir compte de l'efficacité de certains médicaments antimicrobiens lorsqu'ils émettent des recommandations. En outre, les souches d'un organisme peuvent être résistantes à un certain médicament ou à une certaine classe de médicament, même lorsqu'il est couramment efficace contre l'espèce. Ces souches, appelées souches résistantes, présentent un grave problème de santé publique d'une importance croissante pour l'industrie médicale à mesure que la propagation de la résistance aux antibiotiques s'aggrave. La résistance aux antimicrobiens est un problème de plus en plus problématique qui entraîne des millions de décès chaque année.
Alors que la résistance aux médicaments implique généralement des microbes qui inactivent chimiquement un médicament antimicrobien ou une cellule arrêtant mécaniquement l'absorption d'un médicament, une autre forme de résistance aux médicaments peut résulter de la formation de biofilms. Certaines bactéries sont capables de former des biofilms en adhérant à des surfaces sur des dispositifs implantés, par exemple des cathéters et des prothèses, et en créant une matrice extracellulaire à laquelle d'autres cellules adhèrent. Cela leur fournit un environnement stable à partir duquel les bactéries peuvent se disperser et infecter d'autres parties de l'hôte. En outre, la matrice extracellulaire et la couche externe dense de cellules bactériennes peuvent protéger les cellules bactériennes internes des médicaments antimicrobiens.
La microbiologie médicale ne concerne pas seulement le diagnostic et le traitement de tous, elle implique également l'étude de microbes bénéfiques. Les microbes se sont révélés utiles pour combattre les maladies infectieuses et promouvoir la santé. Les traitements peuvent être développés à partir de microbes, comme le démontre la découverte de la pénicilline par Alexander Fleming, ainsi que le développement de nouveaux antibiotiques du genre bactérien Streptomyces parmi beaucoup d'autres. Non seulement les micro-organismes sont une source d'antibiotiques, mais certains peuvent également agir comme probiotics pour fournir des avantages pour la santé de l'hôte, par exemple en améliorant la santé gastro-intestinale ou en inhibant les agents pathogènes.
Agent pathogène
En biologie, un agent pathogène au sens le plus ancien et le plus large du terme, est tout ce qui peut produire une maladie. Un agent pathogène peut également être appelé un agent infectieux ou simplement un germe.
Le terme pathogène est entré en usage dans les années 1880. Généralement, le terme est utilisé pour décrire un micro-organisme ou un agent infectieux, par exemple une bactérie, un protozoaire, un viroïde ou un champignon. Les petits animaux, par exemple certains types de vers et de larves d'insectes, peuvent également produire tous. Néanmoins, ces animaux sont communément appelés, dans le langage courant, des parasites au lieu de pathogènes. L'étude scientifique des organismes microscopiques, y compris les organismes microscopiques pathogènes, est appelée microbiologie, par contre l'étude de tous les agents pouvant inclure ces agents pathogènes est appelée pathologie. La parasitologie, quant à elle, est l'étude scientifique des parasites et des organismes qui les hébergent.
Il existe plusieurs voies par lesquelles les agents pathogènes peuvent envahir un hôte. Les voies principales ont des périodes épisodiques disparates, mais le sol a le potentiel le plus long ou le plus persistant d'abriter un agent pathogène. Les maladies humaines causées par des agents infectieux sont appelées maladies pathogènes, même si toutes les maladies ne sont pas causées par des agents pathogènes. Certaines maladies, comme la maladie de Huntington, sont causées par l'hérédité de gènes anormaux.
Pathogénicité
La pathogénicité est la capacité potentielle des pathogènes à provoquer des maladies. La pathogénicité est liée à la virulence dans le sens, mais certaines autorités en sont venues à la découvrir comme un terme qualitatif, alors que ce dernier est quantitatif. Selon cette norme, un organisme peut être considéré comme pathogène ou non pathogène dans un contexte particulier, mais pas plus pathogène
qu'un autre. De telles comparaisons sont décrites à la place en termes de virulence relative. La pathogénicité est également inégale de la transmissibilité du, qui quantifie le risque d'infection.
Un pathogène peut être décrit en termes de sa capacité à produire des toxines, à pénétrer dans les tissus, à coloniser, à détourner des nutriments et à sa capacité d'immunosuppression de l'hôte.
Pathogénicité dépendante du contexte
Il est courant de parler d'une espèce entière de bactérie comme pathogène lorsqu'elle est identifiée comme la cause d'une maladie (cf. les postulats de Koch). Néanmoins, l'opinion moderne est que la pathogénicité dépend de l'écosystème microbien dans son ensemble. Une bactérie peut participer à des infections opportunistes chez des hôtes immunodéprimés, acquérir des facteurs de virulence par infection plasmidique, être transférée vers un site disparate au sein de l'hôte ou répondre à des changements dans le nombre majoritairement d'autres bactéries présentes. Par exemple, l'infection des ganglions lymphatiques mésentériques de souris avec Yersinia peut effacer le processus de poursuite de l'infection de ces sites par Lactobacillus, éventuellement par un mécanisme de cicatrisation immunologique
.
Concepts associés
Virulence
La virulence (la tendance d'un agent pathogène à réduire l'aptitude d'un hôte) évolue lorsqu'un agent pathogène peut se propager à partir d'un hôte malade, même si l'hôte devient affaibli. La transmission horizontale se produit entre les hôtes de la même espèce, alors que vers la transmission verticale, qui tend à évoluer vers la symbiose (après une période de forte morbidité et mortalité dans la population) en liant le succès évolutif du pathogène au succès évolutif de l'organisme hôte. La biologie évolutive propose que de nombreux agents pathogènes développent une virulence optimale à laquelle l'aptitude acquise par des taux de réplication accrus est contrebalancée par des compromis en matière de transmission réduite, mais les mécanismes exacts sous-jacents à ces relations restent controversés.
Transmission
La transmission d'agents pathogènes se fait par de nombreuses voies disparates, y compris par voie aérienne, directe ou indirecte, par contact sexuel, par le sang, le lait maternel ou un autre liquide corporel, et par la voie fécale-orale.
Types d'agents pathogènes
Prions
Les prions sont des protéines mal repliées qui peuvent transférer leur état mal replié vers une autre protéine principalement repliée du même type. Ils ne contiennent pas de DNA ou RNA et ne peuvent pas en répliquer autre que de convertir des protéines normales déjà existantes à l'état mal replié. Ces protéines anormalement repliées se retrouvent définitivement dans certaines maladies comme la tremblante, l'encéphalopathie spongiforme bovine (maladie de la vache folle) et Creutzfeldt – Jakob ail.
Virus
Les virus sont de petites particules, généralement entre 20 et 300 nanomètres de longueur, contenant RNA ou DNA .es nécessitent une cellule hôte pour se répliquer. Certaines des maladies causées par des agents pathogènes viraux comprennent la variole, la grippe, les oreillons, la rougeole, la varicelle, le virus Ebola, HIV et la rubéole.
Les agents pathogènes appartiennent strictement aux familles: Adenoviridae, Picornaviridae, Herpesviridae, Hepadnaviridae, Flaviviridae, Retroviridae, Orthomyxoviridae, Paramyxoviridae, Papovaviridae, Polyomavirus, Rhabdoviridae et Togaviridae. HIV est un membre notable de la famille Retroviridae qui a touché 37,9 millions de personnes dans le monde en 2018.
Bacteria
La grande majorité des bactéries, dont la longueur peut varier entre 0,15 et 700 μM, sont inoffensives ou bénéfiques pour l'homme. Néanmoins, une liste relativement petite de peut provoquer des maladies infectieuses. Avoir plusieurs façons de causer la maladie. Ils peuvent soit affecter directement les cellules de leur hôte, produire des endotoxines qui endommagent les cellules de leur hôte, soit provoquer une réponse immunitaire suffisamment forte pour endommager les cellules de l'hôte.
L'une des maladies bactériennes les plus lourdes est la tuberculose, causée par la bactérie Mycobacterium tuberculose, qui a tué 1,5 million de personnes en 2013, normalement en Afrique subsaharienne. Contribue à d'autres maladies d'importance mondiale, par exemple la pneumonie, qui peut être causée par des bactéries Streptococcus telles que et Pseudomonas, et des maladies d'origine alimentaire, qui peuvent être causées par des bactéries Shigella telles que, Campylobacter et Salmonella. De même provoquent des infections telles que le tétanos, la fièvre typhoïde, la diphtérie, la syphilis et la lèpre.
Champignons
Les champignons sont des organismes eucaryotes qui peuvent servir d'agents pathogènes. Il existe environ 300 champignons connus qui sont pathogènes pour l'homme, dont le Candida albicans, qui est la cause la plus fréquente du muguet, et le Cryptococcus néoformans, qui peut provoquer une forme grave de méningite. La taille typique des spores fongiques est <4,7 μm de longueur, mais certaines spores peuvent être plus grosses.
Algues
Les algues sont des plantes unicellulaires qui sont clairement non pathogènes malgré l'existence de variétés pathogènes. Protothecosis est une maladie trouvée chez les chiens, les chats, les bovins et les humains causée par un type d'algue verte appelée protothèque qui manque de chlorophylle.
Autres parasites
Certains organismes eucaryotes, y compris un certain nombre de protozoaires et d'helminthes, le sont.
Hôtes pathogènes
Bacteria
Bien que les bactéries puissent être elles-mêmes des agents pathogènes, elles peuvent également être infectées par des agents pathogènes, également appelés phages, qui infectent les bactéries conduisant souvent au death de la bactérie infectée. Les phages T7 et Lamda sont courants. Il y a des virus qui infectent tous les types de bactéries, y compris les Gram négatif et Gram positif. Même ceux qui infectent une autre espèce, y compris les humains, peuvent être infectés par un phage.
Les plantes
Les plantes peuvent héberger un large éventail de types de pathogènes, notamment des bactéries, des champignons, des nématodes et même d'autres plantes. Parmi les plantes notables figurent la tache annulaire de la papaye qui a causé des millions de dollars de dommages aux agriculteurs d'Hawaï et d'Asie du Sud-Est, et la mosaïque du tabac qui a amené le scientifique Martinus Beijerinck à inventer le terme «virus» en 1898. Les agents pathogènes bactériens des plantes sont également un problème causant des taches foliaires, des brûlures et des pourritures chez de nombreuses espèces végétales. Les deux principaux agents pathogènes bactériens pour les plantes sont P. Syringae et R. Solanacearum qui causent le brunissement des feuilles et un autre problème dans les pommes de terre, les tomates et les bananes.
Les champignons sont un autre type d'agent pathogène majeur pour les plantes. Ils peuvent causer une grande variété de problèmes, par exemple une hauteur de plante plus courte, des croissances ou des fosses sur les troncs d'arbres, la pourriture des racines ou des graines et des taches sur les feuilles. Les champignons végétaux courants et graves comprennent le champignon de l'explosion du riz, l'orme hollandais, la brûlure du châtaignier et les maladies du nœud noir et de la pourriture brune des cerises, des prunes et des pêches. On estime que cela entraîne à lui seul une réduction allant jusqu'à 65% du rendement des cultures.
Dans l'ensemble, les plantes ont un large éventail d'agents pathogènes et il a été estimé que seulement 3% de tous les agents pathogènes des plantes peuvent être gérés.
Animaux
Les animaux sont souvent infectés par de nombreux agents pathogènes identiques ou similaires à ceux des humains, notamment des bactéries, des bactéries et des champignons. D'un autre côté, les animaux sauvages sont souvent malades, le plus grand danger étant pour les animaux d'élevage. On estime qu'en milieu rural, 90% ou plus des décès de bétail peuvent être attribués à des agents pathogènes. L'encéphalopathie spongiforme bovine, généralement connue sous le nom de vache folle, est l'une des rares maladies qui affectent les animaux. Une autre maladie animale comprend une variété de troubles de l'immunodéficience qui sont causés par des maladies liées à l'immunodéficience humaine( HIV), y compris BIV et FIV .
Humains
Les humains peuvent être infectés par de nombreux types d'agents pathogènes, y compris des es, des bactéries et des champignons. Les bactéries qui infectent les humains peuvent provoquer des symptômes tels que des éternuements, de la toux, de la fièvre, des vomissements et même conduire à death. Certains de ces symptômes sont causés par lui-même, tandis que d'autres sont causés par l'ordre immunitaire établi de la personne infectée.
Traitement
Prion
Malgré de nombreuses tentatives, à ce jour, aucune thérapie ne s'est avérée capable d'arrêter la progression des maladies.
Virus
Il existe une variété d'options de prévention et de traitement pour certains agents pathogènes viraux. Les vaccins sont une mesure préventive courante et efficace contre divers agents pathogènes viraux. Les vaccins amorcent l'ordre immunitaire établi de l'hôte, de sorte que lorsque l'hôte potentiel le rencontre dans la nature, l'ordre immunitaire établi peut se défendre rapidement contre l'infection. Il existe des vaccins contre la rougeole, les oreillons, la rubéole et la grippe par exemple. Certains, par exemple HIV, la dengue et le chikungunya n'ont pas de vaccins disponibles.
Le traitement des infections virales implique souvent de traiter les symptômes de l'infection plutôt que de fournir un médicament qui affecte le pathogène viral lui-même. Le traitement des symptômes d'une infection virale donne à l'hôte le temps de développer des anticorps contre le pathogène viral qui éliminera alors l'infection. Dans certains cas, un traitement contre le est nécessaire. Un exemple de ceci est HIV où la thérapie antirétrovirale, également connue sous le nom de ART ou HAART, est nécessaire pour empêcher la perte de cellules immunitaires et la progression dans AIDS .
Bacteria
Tout comme les agents pathogènes viraux, l'infection par certains agents pathogènes bactériens peut être évitée grâce à des vaccins. Les vaccins contre les bactéries pathogènes comprennent le vaccin anthrax et le vaccin antipneumococcique. De nombreux autres agents pathogènes bactériens manquent de vaccins à titre préventif, mais l'infection par ces bactéries peut souvent être traitée ou évitée avec des antibiotiques. Les antibiotiques courants comprennent l'amoxicilline, la ciprofloxacine et la doxycycline. Chaque antibiotique a des bactéries disparates contre lesquelles il est efficace et a des mécanismes disparates pour tuer ces bactéries. Par exemple, la doxycycline inhibe la synthèse de nouvelles protéines dans les bactéries à Gram négatif et à Gram positif, ce qui conduit à la death des bactéries affectées.
En raison en partie de la sur-prescription d'antibiotiques dans des circonstances où ils ne sont pas nécessaires, certains agents pathogènes bactériens ont développé une résistance aux antibiotiques et deviennent difficiles à traiter avec les antibiotiques classiques. Une souche génétiquement inégale appelée MRSA est un exemple d'un pathogène bactérien difficile à traiter avec des antibiotiques courants. Un rapport publié en 2013 par le Center for ail Control( CDC) estime que chaque année aux États-Unis, au moins 2 millions de personnes contractent une infection bactérienne résistante aux antibiotiques, et au moins 23 000 personnes meurent de ces infections.
Champignons
L'infection par des agents pathogènes fongiques est traitée avec des médicaments antifongiques. Les infections fongiques telles que le pied d'athlète, les démangeaisons et la teigne sont des infections de la peau et peuvent être traitées avec des médicaments antifongiques topiques comme le clotrimazole. Une autre infection fongique courante comprend les infections par la souche de levure Candida albicans. Candida peut provoquer des infections de la bouche ou de la gorge, généralement appelées muguet, ou il peut provoquer des infections vaginales. Ces infections internes peuvent être traitées soit avec des crèmes antifongiques, soit avec des médicaments oraux. Les médicaments antifongiques courants pour les infections internes comprennent la famille de médicaments Echinocandin et Fluconazole .
Algues
Les algues ne sont généralement pas considérées comme des agents pathogènes, mais le genre Prototheca est connu pour causer des maladies chez les humains. Le traitement de ce type d'infection est actuellement à l'étude et il n'y a pas de cohérence dans le traitement clinique.
Interactions sexuelles
De nombreux agents pathogènes sont capables d'interactions sexuelles. Parmi, l'interaction sexuelle se produit entre les cellules de la même espèce par l'action d'une transformation génétique naturelle. La transformation implique le transfert de DNA d'une cellule donneuse à une cellule receveuse et l'intégration du donneur DNA dans le génome receveur par recombinaison. Des exemples d'agents pathogènes bactériens capables de transformation naturelle sont Helicobacter pylori, Haemophilus influenzae, Legionella pneumophila, Neisseria gonorrhoeae et Streptococcus pneumoniae .
Les agents pathogènes eucaryotes sont souvent capables d'interaction sexuelle par une action impliquant la méiose et la syngamie. La méiose implique l'appariement intime des chromosomes homologous et la recombinaison entre eux. Des exemples d'agents pathogènes eucaryotes capables d'avoir des relations sexuelles comprennent les parasites protozoaires Plasmodium falciparum, Toxoplasma gondii, Trypanosoma brucei, Giardia intestinalis et les champignons Aspergillus fumigatus, Candida albicans et Cryptococcus neoformans.
Les virus peuvent également subir une interaction sexuelle lorsque deux ou plusieurs génomes viraux pénètrent dans la même cellule hôte. Cette action implique l'appariement des génomes homologous et la recombinaison entre eux par une action appelée réactivation de multiplicité. Des exemples de ceux qui subissent cette action sont l'herpès simplex, l'immunodéficience humaine et la vaccine.
Les processus sexuels chez les bactéries, les eucaryotes microbiens et les andes impliquent tous une recombinaison entre les génomes homologous qui semble faciliter la réparation des dommages génomiques infligés au génome des pathogènes par les défenses de leurs hôtes cibles respectifs.
Prion
Les prions sont des protéines mal repliées avec la capacité de transmettre leur forme mal repliée sur des variantes normales de la même protéine. Ils caractérisent plusieurs maladies neurodégénératives mortelles et transmissibles chez l'homme et de nombreux autres animaux. On ne sait pas ce qui cause le mauvais repliement de la protéine normale, mais la structure tridimensionnelle anormale est soupçonnée de conférer des propriétés infectieuses, en réduisant les molécules de protéines voisines dans la même forme. Le mot dérive de «particule infectieuse protéique». L'hypothèse du rôle d'une protéine en tant qu'agent infectieux est valable pour tous les autres agents infectieux connus tels que les bactéries, les champignons et les parasites, qui contiennent tous des acides nucléiques (ADN, RNA ou les deux).
Les variantes prions de la protéine( PrP), dont le service spécifique est incertain, sont présumées être la cause des encéphalopathies spongiformes transmissibles (EST), y compris la tremblante du mouton, la maladie de l'émaciation chronique( CWD) chez le cerf, l'encéphalopathie spongiforme bovine( BSE) chez les bovins (communément appelée «maladie de la vache folle») et Creutzfeldt – Jakob ail( CJD) chez l'homme. Toutes les maladies connues chez les mammifères affectent la structure du cerveau ou d'un autre tissu neural; tous sont progressifs, n'ont pas de traitement efficace connu et sont toujours mortels. Jusqu'en 2015, toutes les maladies connues des mammifères étaient considérées comme causées par la protéine( PrP); néanmoins en 2015 atrophie multiple de l'ordre établi( MSA) s'est avérée transmissible et a été supposée être causée par une forme d'alpha-synucléine.
Les prions forment des agrégats anormaux de protéines appelées amyloïdes, qui s'accumulent dans les tissus infectés et sont associés à des lésions tissulaires et cellulaires death. Les amyloïdes sont également responsables de plusieurs autres maladies neurodégénératives, par exemple la maladie d'Alzheimer et la maladie de Parkinson. Les agrégats sont stables, et cette stabilité structurelle signifie qu'ils résistent à la dénaturation par des agents chimiques et physiques: ils ne peuvent pas être détruits par une désinfection ou une cuisson ordinaire. Cela rend difficile l'élimination et le confinement de ces particules.
Une maladie est un type de protéopathie ou de protéines structurellement anormales. Chez l'homme, on pense que le s est la cause de Creutzfeldt – Jakob ail( CJD), de sa variante( vCJD), du syndrome de Gerstmann – Sträussler – Scheinker( GSS), de l'insomnie familiale fatale( FFI) et kuru. Il y a également des preuves suggérant que peuvent jouer un rôle dans l'action de la maladie d'Alzheimer, de la maladie de Parkinson et de la sclérose latérale amyotrophique( ALS), et celles-ci ont été appelées maladies analogues. Plusieurs protéines de levure ont également été identifiées comme ayant des propriétés génétiques. La réplication est sujette à l'épimutation et à la sélection naturelle tout comme pour les autres formes de réplication, et leur structure varie légèrement entre les espèces.
Protéine prion
Structure
La protéine qui est composée( PrP) se trouve dans tout le corps, même chez les personnes et les animaux en bonne santé. Néanmoins, le PrP trouvé dans le matériel infectieux a une structure disparate et résiste aux protéases, les enzymes du corps qui peuvent principalement décomposer les protéines. La forme normale de la protéine est appelée PrP C, d'autre part la forme infectieuse est appelée PrP Sc- le C se réfère à «cellulaire» PrP, d'autre part le Sc se réfère à la «tremblante», la maladie prototypique, survenant chez les moutons. D'autre part, la PrP Cest structurellement bien définie, la PrP Scest essentiellement polydisperse et définie à un niveau relativement faible. PrP peuvent être induits de fold dans d'autres isoformes plus ou moins bien définies in vitro, et leur relation avec la ou les formes pathogènes in vivo n'est pas encore claire.
PrP C
PrP C est une protéine normale trouvée sur les membranes des cellules. Il a 209 acides aminés (chez l'homme), une liaison disulfure, une masse moléculaire de 35–36 kDa et une structure strictement alpha-hélicoïdale. Plusieurs formes topologiques existent; une forme de surface cellulaire ancrée via un glycolipide et deux formes transmembranaires. La protéine normale n'est pas sédimentable; ce qui signifie qu'il ne peut pas être séparé par des techniques de centrifugation. Son service est un problème complex qui continue d'être étudié. PrP C lie les ions cuivre (II) avec une haute affinité. La signification de cette constatation n'est pas claire, mais elle est présumée se rapporter à la structure ou au service PrP. La PrP Cest facilement digérée par proteinase K et peut être libéré de la surface cellulaire in vitro par l'enzyme phosphoinositide phospholipase C (PI-PLC), qui clive l' ancre glycophosphatidylinositol( GPI) glycolipidique. PrP Il a été rapporté que PrP joue un rôle important dans l'adhésion cellule-cellule et la signalisation intracellulaire in vivo, et peut donc être impliqué dans la communication cellule-cellule dans le cerveau.
PrP res
La protéine de type PrP Scrésistante aux protéases (PrP res) est la dénomination donnée à toute isoforme de PrP cqui est structurellement modifiée et convertie en une forme proteinase K-résistante mal repliée in vitro. Pour modéliser la conversion de PrP Cen PrP Scin vitro, Saborio et al. a rapidement converti la PrP Cen une PrP respar une procédure impliquant une amplification cyclique du mauvais repliement des protéines. Le terme «PrP res» a été utilisé pour découvrir entre PrP Sc, qui est isolée à partir de tissu infectieux et associée à l'agent d'encéphalopathie spongiforme transmissible. Tels que, contrairement à PrPSc, PrP resne sont pas nécessairement infectieux.
PrP Sc
L'isoforme infectieuse de PrP, connue sous le nom de PrP Sc, ou simplement la, est capable de convertir les protéines PrP Cnormales en isoforme infectieuse en modifiant leur conformation ou forme; ceci, à son tour, modifie le processus d'interconnexion des protéines. PrP Scprovoque toujours tout. Bien que la structure 3D exacte de PrP Sc ne soit pas connue, elle a une proportion plus élevée de structure en feuille β plutôt que la structure en hélice α normale. Les agrégations de ces isoformes anormales forment des fibres amyloid hautement structurées, qui s'accumulent pour former des plaques. L'extrémité de chaque fibre agit comme un modèle sur lequel les molécules de protéines libres peuvent se fixer, permettant à la fibre de se développer. Dans la plupart des cas, seulement PrP des molécules ayant une séquence d'acides aminés identique à la PrP Scinfectieuse sont incorporées dans la fibre en croissance. Néanmoins, une transmission inter-espèces rare est également possible.
PrP de service normal
Le service physiologique de la protéine reste mal compris. D'autre part, les données d'expériences in vitro suggèrent de nombreux rôles différents, les études sur les souris PrP knockout n'ont fourni que des informations limitées au motif que ces animaux ne présentent que des anomalies mineures. Dans des recherches effectuées sur des souris, il a été constaté que le clivage des protéines PrP dans les nerfs périphériques provoque l'activation de la réparation myelin dans les cellules de Schwann et que le manque de protéines PrP provoquait une démyélinisation dans ces cellules.
PrP et mort cellulaire régulée
MAVS, RIP1 et RIP3 sont des protéines similaires trouvées dans d'autres parties du corps. Ils polymérisent également en fibres filamenteuses amyloid qui initient la cellule régulée death dans le cas d'une infection virale pour empêcher la propagation des virions à une autre cellule environnante.
PrP et mémoire à long terme
Un examen des preuves en 2005 a suggéré que PrP peut avoir un service normal dans le maintien de la mémoire à long terme. De plus, une étude de 2004 a révélé que les souris dépourvues de gènes pour la protéine cellulaire normale PrP présentent une potentialisation à long terme de l'hippocampe modifiée. Une étude récente qui pourrait expliquer pourquoi cela se révèle que la protéine neuronale CPEB a une séquence génétique similaire aux protéines de levure. La formation similaire de CPEB est essentielle pour maintenir les changements synaptiques à long terme associés à la formation de la mémoire à long terme.
PrP et renouvellement des cellules souches
Un article de 2006 du Whitehead Institute for Biomedical Research indique que le mode PrP ou le mode d'expression sur les cellules souches est nécessaire à l'auto-renouvellement de la moelle osseuse d'un organisme. L'étude a montré que toutes les cellules souches hématopoïétiques à long terme expriment PrP sur leur membrane cellulaire et que les tissus hématopoïétiques avec des cellules souches PrP nulles présentent une sensibilité accrue à la déplétion cellulaire.
PrP et immunité innée
Il existe des preuves que PrP peut jouer un rôle dans l'immunité innée, car le mode ou la manière d'expression du PRNP, le gène PrP, est régulé à la hausse dans de nombreuses infections virales et PrP possède des propriétés antivirales contre de nombreuses infections, notamment HIV .
Réplication du prion
La première hypothèse qui a tenté d'expliquer comment se répliquent d'une manière uniquement protéique était le modèle hétérodimère. Ce modèle suppose qu'une seule molécule PrP Scse lie à une seule molécule PrP Cet catalyse sa conversion en PrP Sc. Les deux PrP Scmolécules viennent alors en dehors et peuvent continuer à convertir plus PrP C. Néanmoins, un modèle de réplication doit expliquer à la fois comment se propagent et pourquoi leur apparition spontanée est si rare. Manfred Eigen a montré que le modèle hétérodimère nécessite que PrP Scsoit un catalyseur extraordinairement efficace, augmentant la vitesse de la réaction de conversion d'un facteur d'environ 10 ¹⁵. Ce problème ne se pose pas si PrP Scn'existe que sous des formes agrégées par exemple amyloid, où la coopérativité peut agir comme une barrière à la conversion spontanée. De plus, malgré un effort considérable, la PrP Scmonomère infectieuse n'a jamais été isolée.
Un modèle alternatif suppose que PrP Scn'existe que sous forme de fibrilles, et que les extrémités de fibrilles se lient à PrP Cet la convertissent en PrP Sc. Si c'était tout, alors la quantité de s augmenterait linéairement, formant des fibrilles de plus en plus longues. Mais une croissance exponentielle à la fois de PrP Sc et de la quantité de particules infectieuses est observée au cours de tout. Cela peut s'expliquer par la prise en compte de la rupture des fibrilles. Une solution mathématique pour le taux de croissance exponentiel résultant de la combinaison de la croissance des fibrilles et de la rupture des fibrilles a été trouvée. Le taux de croissance exponentielle dépend généralement de la racine carrée de la PrP Cconcentration. La période d'incubation est déterminée par la vitesse de croissance exponentielle, et les données in vivo sur les maladies chez les souris transgéniques correspondent à cette prédiction. La même dépendance à la racine carrée est également observée in vitro dans des expériences avec une variété de protéines amyloid disparates .
Le mécanisme de réplication a des implications pour la conception de médicaments. Étant donné que la période d'incubation des maladies est si longue, un médicament efficace n'a pas besoin d'éliminer tout, mais doit simplement ralentir le taux de croissance exponentielle. Les modèles prédisent que le processus le plus efficace pour y parvenir, en utilisant un médicament avec la dose la plus faible possible, est de découvrir un médicament qui se lie aux extrémités des fibrilles et les empêche de plus de croître.
Maladies
Maladies causées par
Animal (s) affecté (s)
ail
Mouton, chèvre (animal (s) affecté (s))
ail
Tremblante
Bovins (animal (s) affecté (s))
ail
La maladie de la vache folle
Chameau (animal (s) affecté (s))
ail
Encéphalopathie spongiforme du chameau( CSE)
Vison (animal (s) affecté (s))
ail
Encéphalopathie transmissible du vison( TME)
Cerf de Virginie, élan, cerf mulet, orignal (animal (s) touché (s))
ail
Émaciation chronique( CWD)
Chat (animal (s) affecté (s))
ail
Encéphalopathie spongiforme féline( FSE)
Nyala, Oryx, Greater Kudu (animal (s) affecté (s))
ail
Encéphalopathie exotique des ongulés (EUE)
Autruche (animal (s) affecté (s))
ail
Encéphalopathie spongiforme (ne s'est pas avérée transmissible.)
Humain (animal (s) affecté (s))
ail
Creutzfeldt – Jakob ail( CJD)
Iatrogène Creutzfeldt – Jakob ail (iCJD)
Variante Creutzfeldt – Jakob ail( vCJD)
Familial Creutzfeldt – Jakob ail (fCJD)
Creutzfeldt-Jakob ail sporadique (sCJD)
Syndrome de Gerstmann – Sträussler – Scheinker( GSS)
Insomnie familiale fatale( FFI)
Kuru
Encéphalopathie spongiforme familiale
Maladie sensible à la protéase variable (VPSPr)
Les prions provoquent une maladie neurodégénérative en s'agrégeant extracellulairement dans l'ordre établi du système nerveux central pour former des plaques appelées amyloid, qui perturbent la structure tissulaire normale. Cette perturbation est caractérisée par des «trous» dans le tissu avec une architecture spongieuse résultante pour la raison que la formation de vacuoles dans les neurones. Un autre changement histologique comprend l'astrogliose et l'absence de réaction inflammatoire. En revanche, la période d'incubation des maladies est relativement longue (5 à 20 ans), une fois que les symptômes apparaissent, la maladie progresse rapidement, entraînant des lésions cérébrales et death. Les symptômes neurodégénératifs peuvent inclure des convulsions, la démence, l'ataxie (dysfonctionnement de l'équilibre et de la coordination) et des changements de comportement ou de personnalité.
Toutes les maladies connues sont incurables et mortelles. Néanmoins, un vaccin développé chez la souris peut fournir un aperçu de la fourniture d'un vaccin pour résister aux infections chez l'homme. En outre, en 2006, les scientifiques ont annoncé qu'ils avaient des bovins génétiquement modifiés dépourvus d'un gène nécessaire à la production - ce qui les rend théoriquement immunisés contre BSE, en s'appuyant sur des recherches indiquant que les souris dépourvues de protéines principalement présentes sont résistantes à l'infection par la protéine de tremblante. En 2013, une étude a révélé que 1 personne sur 2 000 au Royaume-Uni pourrait héberger la protéine infectieuse qui cause vCJD .
De nombreuses espèces de mammifères disparates peuvent être affectées par des maladies, car la protéine( PrP) est très similaire chez tous les mammifères. Pour la raison que de petites différences dans PrP entre des espèces disparates, il est inhabituel pour une espèce de transmettre d'une espèce à l'autre. On pense néanmoins que la variante humaine Creutzfeldt – Jakob ail est causée par un virus qui infecte couramment les bovins, provoquant une encéphalopathie spongiforme bovine et se transmet par la viande infectée.
Jusqu'en 2015, toutes les maladies connues des mammifères étaient considérées comme causées par la protéine, PrP ; en 2015, une atrophie multiple d'ordre établi s'est avérée transmissible et a été supposée être causée par une nouvelle forme mal repliée d'une protéine appelée alpha-synucléine. La forme endogène et correctement repliée de la protéine est désignée PrP C(pour Common ou Cellular), en revanche la forme mal repliée liée à la maladie est désignée PrP Sc (pour Scrapie), après l'une des maladies d'abord liées à la neurodégénérescence. La structure précise du n'est pas connue, même si elles peuvent être formées en combinant PrP C, l'acide polyadénylique et les lipides dans une réaction d'amplification cyclique de repliement incorrect des protéines (PMCA). Cette opération prouve par ailleurs que la réplication n'est pas dépendante des acides nucléiques.
Transmission
Il a été reconnu que les maladies peuvent survenir de trois manières différentes: acquise, familiale ou sporadique. On suppose souvent que la forme malade interagit directement avec la forme normale pour lui faire réorganiser sa structure. Une idée, l'hypothèse «Protein X», est qu'une protéine cellulaire non encore identifiée (Protein X) permet la conversion de PrP Cen PrP Scen rassemblant une molécule de chacun des deux en un complex .
La principale opération d'infection chez les animaux se fait par ingestion. On pense que ces substances peuvent être déposées dans l'environnement par les restes d'animaux morts et par l'urine, la salive et d'autres liquides organiques. Ils peuvent ensuite s'attarder dans le sol en se liant à l'argile et à d'autres minéraux.
Une équipe de recherche de l'Université de Californie a fourni des preuves de la théorie selon laquelle l'infection peut provenir du fumier. Et, comme le fumier est présent dans de nombreuses zones entourant les réservoirs d'eau, en plus d'être utilisé dans de nombreux champs de culture, il augmente la possibilité d'une transmission généralisée. Il a été rapporté en janvier 2011 que des chercheurs avaient découvert une propagation par transmission aérienne sur des particules d'aérosol, lors d'une expérience de test sur des animaux en relation avec une infection par la tremblante chez des souris de laboratoire. Des preuves préliminaires à l'appui de la notion de transmission possible par l'utilisation de gonadotrophine ménopausique humaine dérivée d'urine, administrée pour le traitement de l'infertilité, ont été publiées en 2011.
Prions dans les plantes
En 2015, des chercheurs du Health Science Center de l'Université du Texas à Houston ont découvert que les plantes peuvent être un vecteur de fors. Lorsque les chercheurs ont nourri de l'herbe de hamsters qui poussait sur le sol où un cerf mort avec une dépérissement chronique( CWD) a été enterré, les hamsters sont tombés malades avec CWD, suggérant que cela peut se lier aux plantes, qui les prennent ensuite dans la feuille. et la structure de la tige, où ils peuvent être consommés par les herbivores, complétant ainsi le cycle. Il est par conséquent possible qu'il y ait un nombre de ofs qui s'accumule progressivement dans l'environnement.
Stérilisation
Les particules infectieuses possédant un acide nucléique en dépendent pour diriger leur réplication continue. Néanmoins, elles sont infectieuses par leur effet sur les versions normales de la protéine. La stérilisation nécessite donc la dénaturation de la protéine à un état dans lequel la molécule n'est plus capable d'induire le repliement anormal des protéines normales. Généralement, les s sont assez résistants aux protéases, à la chaleur, aux rayonnements ionisants et aux traitements au formaldéhyde, bien que leur pouvoir infectieux puisse être réduit par de tels traitements. Une décontamination efficace repose sur l'hydrolyse des protéines ou la réduction ou la destruction de la structure tertiaire des protéines. Les exemples incluent l'hypochlorite de sodium, l'hydroxyde de sodium et les détergents fortement acides par exemple LpH. 134 ° C (273 ° F) pendant 18 minutes dans un autoclave à vapeur sous pression s'est avéré quelque peu efficace pour désactiver l'agent de tous. La stérilisation à l'ozone est actuellement à l'étude en tant qu'opération potentielle de dénaturation et de désactivation. La renaturation d'un état complètement dénaturé à un statut infectieux n'a pas encore été réalisée; néanmoins, les personnes partiellement dénaturées peuvent être renaturées à un statut infectieux dans certaines conditions artificielles.
L'Organisation mondiale de la santé recommande l'une des trois procédures suivantes pour la stérilisation de tous les instruments chirurgicaux résistants à la chaleur afin de garantir qu'ils ne sont pas contaminés par:
Immerger dans de l'hydroxyde de sodium 1N et placer dans un autoclave à déplacement par gravité à 121 ° C pendant 30 minutes; nettoyer; rincer à l'eau; puis exécutez les processus de stérilisation de routine.
Immerger dans l'hypochlorite de sodium 1N (20 000 parties par million de chlore disponible) pendant 1 heure; transférer les instruments dans l'eau; chauffer dans un autoclave à déplacement par gravité à 121 ° C pendant 1 heure; nettoyer; puis exécutez les processus de stérilisation de routine.
Immerger dans de l'hydroxyde de sodium 1N ou de l'hypochlorite de sodium (20 000 parties par million de chlore disponible) pendant 1 heure; retirer et rincer à l'eau, puis transférer dans une casserole ouverte et chauffer dans un autoclave à déplacement par gravité (121 ° C) ou dans un autoclave à charge poreuse (134 ° C) pendant 1 heure; nettoyer; puis exécutez les processus de stérilisation de routine.
Résistance à la dégradation dans la nature
Des preuves accablantes montrent qu'ils résistent à la dégradation et persistent dans l'environnement pendant des années, et que les protéases ne les dégradent pas. Des preuves expérimentales montrent que les non-liés se dégradent avec le temps, d'un autre côté, les limites du sol restent à des niveaux stables ou croissants, ce qui suggère que ces dernières s'accumulent probablement dans l'environnement.
Champignons
Des protéines présentant un comportement de type se trouvent également dans certains champignons, ce qui a été utile pour aider à comprendre les mammifères. Les champignons ne semblent pas causer de maladie chez leurs hôtes. Chez la levure, le repliement des protéines vers la configuration est assisté par des protéines chaperons, par exemple Hsp104. Tous les produits connus induisent la formation d'un amyloid fold, dans lequel la protéine polymérise en un agrégat constitué de feuilles bêta compactées. Les agrégats amyloïdes sont des fibrilles qui poussent à leurs extrémités et se répliquent lorsque la rupture fait que deux extrémités en croissance deviennent quatre extrémités en croissance. La période d'incubation des maladies est déterminée par le taux de croissance exponentiel associé à la réplication, qui est un équilibre entre la croissance linéaire et la rupture des agrégats.
Des protéines fongiques présentant un changement conformationnel basé sur un modèle ont été découvertes dans la levure Saccharomyces cerevisiae par Reed Wickner au début des années 1990. Pour leur similitude mécanique avec les mammifères, ils ont été appelés levures. Par la suite, a a également été trouvé dans le champignon Podospora anserina. Les thèses se comportent en plus de PrP, mais, généralement, ne sont pas toxiques pour leurs hôtes. Le groupe de Susan Lindquist à l'Institut Whitehead a fait valoir que certains des champignons ne sont associés à aucun état, mais peuvent avoir un rôle utile; néanmoins, les chercheurs du NIH ont également fourni des arguments suggérant que les champignons pourraient être considérés comme un état malade. Il est prouvé que les protéines fongiques ont développé des fonctions spécifiques qui sont bénéfiques pour le micro-organisme qui améliorent leur capacité à s'adapter à leurs divers environnements.
La recherche sur les champignons a fortement soutenu le concept de protéine uniquement, car il a été démontré que la protéine purifiée extraite de cellules avec un état convertissait la forme normale de la protéine en une forme mal repliée in vitro et, dans l'action, préserve les informations correspondantes. aux tensions disparates de l'État. Il a également fait la lumière sur les domaines, qui sont des régions d'une protéine qui favorisent la conversion en a. Les champignons ont aidé à suggérer des mécanismes de conversion qui peuvent s'appliquer à tous, même si les champignons semblent inégaux des mammifères infectieux en l'absence de cofacteur nécessaire à la propagation. Les domaines caractéristiques peuvent varier entre les espèces - par exemple, les domaines fongiques caractéristiques ne sont pas trouvés chez les mammifères.
Prions fongiques
Protéine
Hôte naturel
Fonction normale
État du prion
Phénotype du prion
Année identifiée
Hôte naturel - Ure2p (Protéine)
Saccharomyces cerevisiae
Fonction normale - Ure2p (Protéine)
Répresseur catabolite azoté
État du prion - Ure2p (protéine)
(URE3)
Phénotype du prion - Ure2p (Protéine)
Croissance sur des sources d'azote pauvres
Année identifiée - Ure2p (Protéine)
1994
Hôte naturel - Sup35p (Protéine)
S. Cerevisiae
Fonction normale - Sup35p (protéine)
Facteur de terminaison de la traduction
État prion - Sup35p (Protéine)
(PSI +)
Phénotype Prion - Sup35p (Protéine)
Augmentation des niveaux de suppression de non-sens
Année identifiée - Sup35p (Protéine)
1994
Hôte naturel - HET-S (protéine)
Podospora anserina
Fonction normale - HET-S (protéine)
Régule l' incompatibilité heterokaryon
État du prion - HET-S (protéine)
(Het-s)
Phénotype Prion - HET-S (Protéine)
Formation d'hétérocaryons entre souches incompatibles
Année identifiée - HET-S (Protéine)
Rien
Hôte naturel - Rnq1p (protéine)
S. Cerevisiae
Fonction normale - Rnq1p (protéine)
Facteur de modèle de protéine
État du prion - Rnq1p (protéine)
(RNQ +), (PIN +)
Phénotype Prion - Rnq1p (Protéine)
Favorise l'agrégation des autres
Année identifiée - Rnq1p (Protéine)
Rien
Hôte naturel - Swi1 (Protéine)
S. Cerevisiae
Fonction normale - Swi1 (protéine)
Remodelage de la chromatine
État du prion - Swi1 (protéine)
(SWI +)
Phénotype Prion - Swi1 (Protéine)
Faible croissance sur certaines sources de carbone
Année identifiée - Swi1 (Protéine)
2008
Hôte naturel - Cyc8 (protéine)
S. Cerevisiae
Fonction normale - Cyc8 (protéine)
Répresseur transcriptionnel
État du prion - Cyc8 (protéine)
(OCT +)
Phénotype Prion - Cyc8 (Protéine)
Dérépression transcriptionnelle de plusieurs gènes
Année identifiée - Cyc8 (Protéine)
2009
Hôte naturel - Mot3 (Protéine)
S. Cerevisiae
Fonction normale - Mot3 (Protéine)
Facteur de copie nucléaire
État du prion - Mot3 (protéine)
(MOT3 +)
Phénotype prion - Mot3 (Protéine)
Dérépression transcriptionnelle des gènes anaérobies
Année identifiée - Mot3 (Protéine)
2009
Hôte naturel - Sfp1 (Protéine)
S. Cerevisiae
Fonction normale - Sfp1 (protéine)
Facteur de copie putatif
État prion - Sfp1 (Protéine)
(FAI +)
Phénotype Prion - Sfp1 (Protéine)
Antisuppression
Année identifiée - Sfp1 (Protéine)
2010
Traitements
Il n'existe pas de traitements efficaces contre les maladies. Les essais cliniques chez l'homme n'ont pas rencontré de succès et ont été entravés par la rareté des maladies. Bien que certains traitements potentiels se soient révélés prometteurs en laboratoire, aucun n'a été efficace une fois que la maladie s'est installée.
Dans une autre maladie
Des domaines de type prion ont été trouvés dans une variété d'autres protéines de mammifères. Certaines de ces protéines ont été impliquées dans l'ontogénie des troubles neurodégénératifs liés à l'âge comme par exemple la sclérose latérale amyotrophique( ALS) un neurone moteur, la dégénérescence lobaire frontotemporale avec inclusions ubiquitine-positives (FTLD-U), la maladie d'Alzheimer, la maladie de Parkinson et la maladie de Huntington. Ils sont également impliqués dans certaines formes d'amylose systémique, y compris l'amylose AA, qui se développe chez les humains et les animaux atteints de maladies inflammatoires et infectieuses telles que la tuberculose, la maladie de Crohn, la polyarthrite rhumatoïde et HIV AIDS. L'amylose AA, comme toutes les autres, peut être transmissible. Cela a donné naissance au «paradigme du prion», dans lequel des protéines autrement inoffensives peuvent être converties en une forme pathogène par un petit nombre de protéines nucléantes mal repliées.
La définition du domaine a-like découle de l'étude des champignons. Dans la levure, les protéines ogéniques ont un domaine portable qui est à la fois nécessaire et suffisant pour l'auto-modélisation et l'agrégation des protéines. Ceci a été montré en attachant le domaine à une protéine rapporteur, qui s'agrège ensuite comme une protéine connue. De plus, la suppression du domaine d'une protéine fongique inhibe la genèse. Cette vision modulaire du comportement a conduit à l'hypothèse que des domaines similaires sont présents dans les protéines animales, en plus de PrP. Ces domaines fongiques ont plusieurs caractéristiques de séquence caractéristiques. Ils sont couramment enrichis en résidus asparagine, glutamine, tyrosine et glycine, un biais asparagine étant spécifiquement propice à la propriété agrégative des. Historiquement, l'ogenèse a été considérée comme indépendante de la séquence et uniquement dépendante de la teneur relative en résidus. Néanmoins, cela s'est avéré être faux, l'espacement des prolines et des résidus chargés s'étant avéré être critique dans la formation de amyloid .
Les criblages bioinformatiques ont prédit que plus de 250 protéines humaines contiennent des domaines analogues (PrLD). On suppose que ces domaines ont les mêmes propriétés transmissibles et amyloïdogènes de PrP et des protéines fongiques connues. Comme dans la levure, les protéines impliquées dans le mode ou le mode d'expression génique et la liaison RNA semblent être spécifiquement enrichies en PrLD, par rapport à d'autres classes de protéines. Spécialement, 29 des protéines connues 210 avec un RNA reconnaissance motif ont également un domaine putatif. Pendant ce temps, plusieurs de ces protéines de liaison à l'ARN ont été indépendamment identifiées comme pathogènes dans les cas de ALS, de FTLD-U, de maladie d'Alzheimer et de maladie de Huntington.
Rôle dans les maladies neurodégénératives
On suppose que la pathogénicité des et des protéines avec des domaines similaires provient de leur capacité d'auto-modélisation et de la croissance exponentielle résultante des fibrilles amyloid. La présence de fibrilles amyloid chez les patients atteints de maladies dégénératives a été bien documentée. Ces fibrilles amyloid sont considérées comme le résultat de protéines pathogènes qui s'auto-propagent et forment des agrégats non fonctionnels très stables. D'autre part, cela n'implique pas nécessairement une relation causale entre amyloid et les maladies dégénératives, la toxicité de certaines formes amyloid et la surproduction de amyloid dans les cas familiaux de troubles dégénératifs soutient l'idée que amyloid la formation est clairement toxique.
Plus précisément, une agrégation de TDP-43, une protéine de liaison à l'ARN, a été trouvée chez des patients ALS / MND, et des mutations dans les gènes codant pour ces protéines ont été identifiées dans des cas familiaux de ALS / MND. Ces mutations favorisent le mauvais repliement des protéines en conformation de type a. La forme mal repliée du TDP-43 forme des inclusions cytoplasmiques dans les neurones atteints, et se trouve appauvrie dans le noyau. En plus de ALS / MND et FTLD-U, la pathologie TDP-43 est un aspect de nombreux cas de maladie d'Alzheimer, de Parkinson et de Huntington. Le mauvais repliement du TDP-43 est généralement dirigé par son domaine similaire. Ce domaine est intrinsèquement sujet à un mauvais repliement, par contre des mutations pathologiques dans le TDP-43 ont été trouvées pour augmenter cette propension à mal se replier, expliquant la présence de ces mutations dans les cas familiaux de ALS / MND. Comme dans la levure, le domaine similaire de TDP-43 s'est avéré être à la fois nécessaire et suffisant pour le mauvais repliement et l'agrégation des protéines.
De même, des mutations pathogènes ont été identifiées dans les domaines analogues des riboprotéines nucléaires hnRNPA2B1 et hnRNPA1 hétérogènes dans des cas familiaux de dégénérescence des muscles, du cerveau, des os et des motoneurones. La forme sauvage de toutes ces protéines montre une tendance à s'auto-assembler en amyloid fibrilles, par contre les mutations pathogènes exacerbent ce comportement et conduisent à une accumulation excessive.
Etymologie et prononciation
Le mot, inventé en 1982 par Stanley B. Prusiner, est un portemanteau dérivé de protéines et d'infections, inévitablement, et est l'abréviation de «protéine infectieuse particulaire», en référence à sa capacité à s'auto-propager et à transmettre sa conformation à une autre protéine. Sa prononciation principale est / ˈpriːɒn / (écouter), malgré / ˈpraɪɒn /, comme la dénomination homographique de l'oiseau est prononcée, est également entendue. Dans son article de 1982 introduisant le terme, Prusiner spécifiait qu'il était «prononcé avant».
Virus
Un virus est un agent infectieux submicroscopique qui se réplique uniquement à l'intérieur des cellules vivantes d'un organisme.es peut infecter tous les types de formes de vie, des animaux et des plantes aux micro-organismes, y compris les bactéries et les archées.Depuis l'article de Dmitri Ivanovsky de 1892 décrivant un pathogène non bactérien infectant les plants de tabac, et la découverte de la mosaïque du tabac par Martinus Beijerinck en 1898, plus de 6 000 espèces ont été décrites en détail, parmi les millions de types d'œufs présents dans l'environnement, on en trouve dans presque tous les écosystèmes de la Terre et sont le type d'entité biologique le plus nombreux. L'étude ofes est connue sous le nom de virologie, une sous-spécialité de la microbiologie.
Lorsqu'elle est infectée, une cellule hôte est obligée de produire rapidement des milliers de copies identiques de l'original. Lorsqu'ils ne se trouvent pas à l'intérieur d'une cellule infectée ou qu'ils sont en train d'infecter une cellule, ils existent sous la forme de particules indépendantes, ou virions, consistant en: (i) le matériel génétique, c'est-à-dire les molécules longues de DNA ou RNA qui codent la structure des protéines par lesquelles agit; (ii) une enveloppe protéique, la capside, qui entoure et protège le matériel génétique; et dans certains cas (iii) une enveloppe extérieure de lipides. Les formes de ces particules vont de simples formes hélicoïdales et icosaédriques à des structures plus complex. La plupart des espèces ont des virions trop petits pour être vus au microscope optique, car ils font un centième de la taille de la plupart des bactéries.
Les origines de l'histoire évolutive de la vie ne sont pas claires: certains peuvent avoir évolué à partir de plasmides - des morceaux de DNA qui peuvent se déplacer entre les cellules - tandis que d'autres peuvent avoir évolué à partir de bactéries. Dans l'évolution, les es sont un moyen important de transfert horizontal de gènes, ce qui augmente la diversité génétique dans un processus analogue à la reproduction sexuée.es sont considérés par certains biologistes comme une forme de vie, au motif qu'ils transportent du matériel génétique, se reproduisent et évoluent par la sélection naturelle, en dépit de leur manque de caractéristiques clés (telles que la structure cellulaire) qui sont clairement considérées comme nécessaires pour dénombrer la vie. Au motif qu'ils possèdent certaines de ces qualités, mais pas toutes, ils ont été décrits comme des «organismes à la lisière de la vie» et comme des réplicateurs.
Les virus se propagent de plusieurs manières. Une voie de transmission passe par des organismes porteurs de maladies connus sous le nom de vecteurs: tels que, les es sont souvent transmis d'une plante à l'autre par des insectes qui se nourrissent de la sève des plantes, par exemple les pucerons; les andes chez les animaux peuvent être transportées par des insectes suceurs de sang. La grippe se transmet par la toux et les éternuements. Les norovirus et les rotavirus, causes fréquentes de gastro-entérite virale, sont transmis par voie fécale-orale, passés par contact et pénétrant dans le corps dans les aliments ou l'eau. HIV fait partie de plusieurs transmissions par contact sexuel et par exposition à du sang






